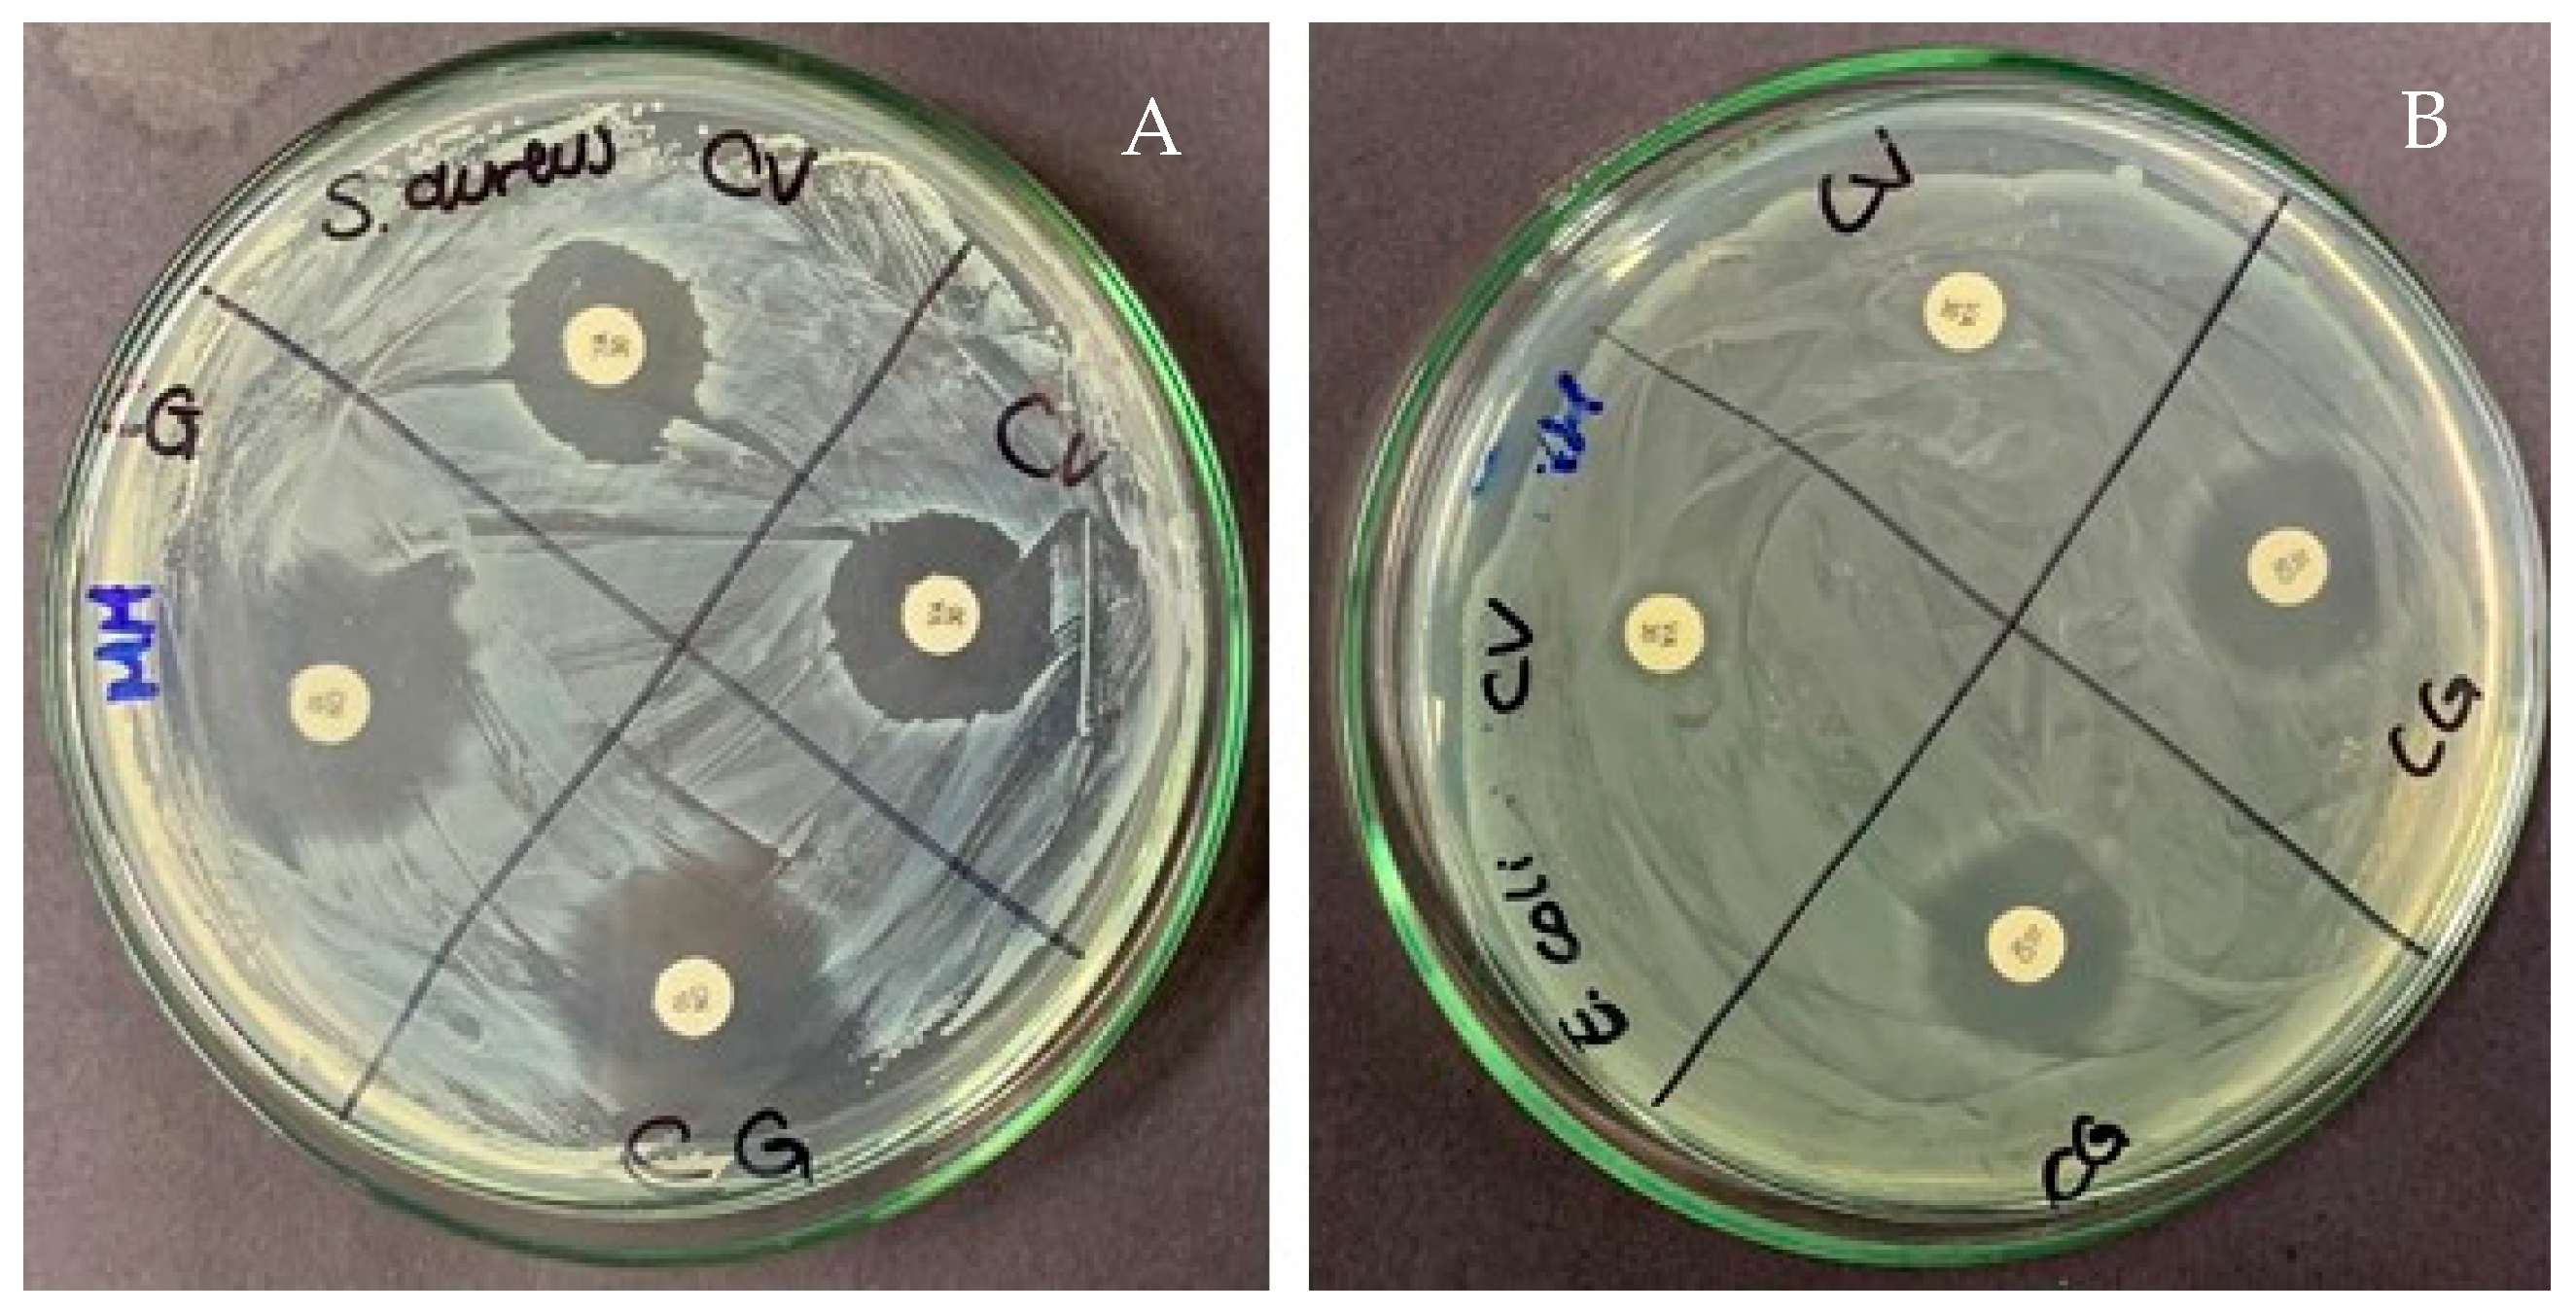
Gels 10 00234 g007

Development and Characterization of a Hand Rub Gel Produced with Artisan Alcohol (Puntas), Silver Nanoparticles, and Saponins from Quinoa
Abstract
1. Introduction
2. Results and Discussion
2.1. Gel Formulations Based on Visual Consistency
2.2. pH and Organoleptic Evaluation
2.3. Rheological Behavior
2.3.1. Rotational Test
2.3.2. Oscillatory Test
2.4. Texture Profile Analysis
2.5. Fourier-Transform Infrared Spectra of Gels
2.6. Morphology by Scanning Electron Microscope (SEM)
2.7. Antimicrobial Activity
3. Materials and Methods
3.1. Gel preparation Process
3.2. pH and Organoleptical Determinations
3.3. Rheological Behavior
3.3.1. Rotational Test
3.3.2. Oscillatory Test
3.4. Texture Profile Analysis
3.5. Fourier-Transform Infrared Spectra of Gels
3.6. Scanning Electron Microscope (SEM)
3.7. Antimicrobial Activity
3.7.1. Microorganisms
3.7.2. Well-Diffusion Method
3.8. Statistical Analysis
4. Conclusions
Author Contributions
Funding
Institutional Review Board Statement
Informed Consent Statement
Data Availability Statement
Acknowledgments
Conflicts of Interest
References
- Ariyanthini, K.S.; Angelina, E.; Permana, K.N.B.; Thelmalina, F.J.; Prasetia, I. Antibacterial activity testing of hand sanitizer gel extract of coriander (Coriandrum sativum L.) Seeds against Staphylococcus aureus. J. Pharm. Sci. Appl. 2021, 3, 98–107. [Google Scholar] [CrossRef]
- Ma, Y.; Yi, J.; Ma, J.; Yu, H.; Luo, L.; Wu, W.; Jin, L.; Yang, Q.; Lou, T.; Sun, D. Hand sanitizer gels: Classification, challenges, and the future of multipurpose hand hygiene products. Toxics 2023, 11, 687. [Google Scholar] [CrossRef] [PubMed]
- Imani, S.M.; Ladouceur, L.; Marshall, T.; Maclachlan, R.; Soleymani, L.; Didar, T.F. Antimicrobial nanomaterials and coatings: Current mechanisms and future perspectives to control the spread of viruses including SARS-CoV-2. ACS Nano 2020, 14, 12341–12369. [Google Scholar] [CrossRef]
- Mallakpour, S.; Azadi, E.; Hussain, C.M. Protection, disinfection, and immunization for healthcare during the COVID-19 pandemic: Role of natural and synthetic macromolecules. Sci. Total Environ. 2021, 776, 145989. [Google Scholar] [CrossRef]
- Ontong, J.C.; Singh, S.; Nwabor, O.F.; Chusri, S.; Voravuthikunchai, S.P. Potential of antimicrobial topical gel with synthesized biogenic silver nanoparticle using Rhodomyrtus tomentosa leaf extract and silk sericin. Biotechnol. Lett 2020, 42, 2653–2664. [Google Scholar] [CrossRef]
- Rai, N.; Shukla, T.P.; Loksh, K.R.; Karole, S. Synthesized silver nanoparticle loaded gel of Curcuma caesia for effective treatment of acne. J. Drug. Del. Ther. Clin. Risk Manag. 2020, 10, 75–82. [Google Scholar] [CrossRef]
- Islam, M.A.; Jacob, M.V.; Antunes, E. A critical review on silver nanoparticles: From synthesis and applications to its mitigation through low-cost adsorption by biochar. J. Environ. Manag. 2021, 281, 111918. [Google Scholar] [CrossRef] [PubMed]
- Yin, I.X.; Zhang, J.; Zhao, I.S.; Mei, M.L.; Li, Q.; Chu, C.H. The Antibacterial Mechanism of Silver Nanoparticles and Its Application in Dentistry. Int. J. Nanomed. 2020, 15, 2555–2562. [Google Scholar] [CrossRef]
- Gashaw, G.; Fassil, A.; Redi, F. Evaluation of the antibacterial activity of Pleurotus spp. cultivated on different agricultural wastes in Chiro, Ethiopia. Int. J. Microbiol. 2020, 2020, 9312489. [Google Scholar] [CrossRef]
- Dwivedi, M.K.; Sonter, S.; Mishra, S.; Patel, D.K.; Singh, P.K. Antioxidant, antibacterial activity, and phytochemical characterization of Carica papaya flowers. Beni-Suef Univ. J. Basic Appl. Sci. 2020, 9, 23. [Google Scholar] [CrossRef]
- Chojnacka, K.; Witek-Krowiak, A.; Skrzypczak, D.; Mikula, K.; Młynarz, P. Phytochemicals containing biologically active polyphenols as an effective agent against COVID-19-inducing coronavirus. J. Funct. Foods 2020, 73, 104146. [Google Scholar] [CrossRef] [PubMed]
- Huynh, N.K.; Nguyen, D.H.M.; Nguyen, H.V.H. Effects of processing on oxalate contents in plant foods: A review. J. Food Compost. Anal. 2022, 112, 104685. [Google Scholar] [CrossRef]
- Takahashi, C.; Vílchez, H.; Poemape, J.; Alvia, A.; Olortegui, A. Diversity of bioactive compounds from Tropaeolum tuberosum (mashua). Rev. Colomb. Cienc. Quim. Farm. 2023, 52, 1233. [Google Scholar]
- Acurio, L.P.; Salazar, D.M.; Valencia, A.F.; Robalino, D.R.; Barona, A.C.; Alvarez, F.C.; Rodriguez, C.A. Antimicrobial potential of Chlorella algae isolated from stacked waters of the Andean Region of Ecuador. IOP Conf. Ser. Earth Environ. Sci. 2018, 151, 012040. [Google Scholar] [CrossRef]
- Little, S.M.; Senhorinho, G.N.A.; Saleh, M.; Basiliko, N.; Scott, J.A. Antibacterial compounds in green microalgae from extreme environments: A review. Algae 2021, 36, 61–72. [Google Scholar] [CrossRef]
- Syukri, D.M.; Nwabor, O.F.; Singh, S.; Ontong, J.C.; Wunnoo, S.; Paosen, S.; Munah, S.; Voravuthikunchai, S.P. Antibacterial-coated silk surgical sutures by ex situ deposition of silver nanoparticles synthesized with Eucalyptus camaldulensis eradicates infections. J. Microbiol. Methods 2020, 174, 105955. [Google Scholar] [CrossRef] [PubMed]
- Tummino, M.L.; Laurenti, E.; Bracco, P.; Cecone, C.; Parola, V.L.; Vineis, C.; Testa, M.L. Antibacterial properties of functionalized cellulose extracted from deproteinized soybean hulls. Cellulose 2023, 30, 7805–7824. [Google Scholar] [CrossRef]
- Tripathy, D.; Gadtya, A.S.; Moharana, S. Supramolecular Gel, Its classification, preparation, properties, and applications: A review. Polym.-Plast. Technol. Mater. 2023, 62, 306–326. [Google Scholar] [CrossRef]
- Talat, M.; Zaman, M.; Khan, R.; Jamshaid, M.; Akhtar, M.; Mirza, A.Z. Emulgel: An effective drug delivery system. Drug Dev. Ind. Pharm. 2021, 47, 1193–1199. [Google Scholar] [CrossRef]
- Mohd Shahrizan, M.S.; Abd Aziz, Z.H.; Katas, H. Fluid gels: A systematic review towards their application in pharmaceutical dosage forms and drug delivery systems. J. Drug Deliv. Sci. Technol. 2022, 67, 102947. [Google Scholar] [CrossRef]
- Martín-Illana, A.; Notario-Pérez, F.; Cazorla-Luna, R.; Ruiz-Caro, R.; Bonferoni, M.C.; Tamayo, A.; Veiga, M.D. Bigels as drug delivery systems: From their components to their applications. Drug Discov. Today 2022, 27, 1008–1026. [Google Scholar] [CrossRef] [PubMed]
- Ho, T.-C.; Chang, C.-C.; Chan, H.-P.; Chung, T.-W.; Shu, C.-W.; Chuang, K.-P.; Duh, T.-H.; Yang, M.-H.; Tyan, Y.-C. Hydrogels: Properties and Applications in Biomedicine. Molecules 2022, 27, 2902. [Google Scholar] [CrossRef]
- Suchomel, M.; Steinmann, J.; Kampf, G. Efficacies of the original and modified World Health Organization-recommended hand-rub formulations. J. Hosp. Infect. 2020, 106, 264–270. [Google Scholar] [CrossRef]
- Villa, C.; Russo, E. Hydrogels in Hand Sanitizers. Materials 2021, 14, 1577. [Google Scholar] [CrossRef] [PubMed]
- Boyce, J.; Chartier, Y.; Chraiti, M.; Cookson, B.; Damani, N.; Dharan, S. WHO. Guidelines on Hand Hygiene in Health Care. First Global Patient Safety Challenge Clean Care Is Safer Care. Available online: https://pubmed.ncbi.nlm.nih.gov/23805438/ (accessed on 2 February 2024).
- Aswathy, S.; Narendrakumar, U.; Manjubala, I. Commercial hydrogels for biomedical applications. Heliyon 2020, 6, e03719. [Google Scholar] [CrossRef] [PubMed]
- Berardi, A.; Perinelli, D.R.; Merchant, H.A.; Bisharat, L.; Basheti, I.A.; Bonacucina, G.; Cespi, M.; Palmieri, G.F. Hand sanitisers amid COVID-19: A critical review of alcohol-based products on the market and formulation approaches to respond to increasing demand. Int. J. Pharm. 2020, 584, 119431. [Google Scholar] [CrossRef]
- Lin, Q.; Lim, J.Y.; Xue, K.; Yew, P.Y.M.; Owh, C.; Chee, P.L.; Loh, X.J. Sanitizing agents for virus inactivation and disinfection. View 2020, 1, e16. [Google Scholar] [CrossRef]
- Hans, M.; Lugani, Y.; Chandel, A.K.; Rai, R.; Kumar, S. Production of first-and second-generation ethanol for use in alcohol-based hand sanitizers and disinfectants in India. Biomass Convers. Biorefin 2023, 13, 7423–7440. [Google Scholar] [CrossRef]
- Monsalve, M.S. Bebidas ancestrales y tradicionales de Colombia (Región del Pacífico). Sosquua 2020, 2, 57–66. [Google Scholar] [CrossRef]
- Valdés-Solano, D.M.; Fonseca-Herreño, L.C.; Alba-Maldonado, J.M. Diagnostic tools for measuring the manufacture of Colombian traditional emerging products. J. Phys. Conf. Ser. 2020, 1513, 012019. [Google Scholar] [CrossRef]
- Viana, E.J.; de Carvalho Tavares, I.M.; Rodrigues, L.M.A.; das Graças Cardoso, M.; Júnior, J.C.B.; Gualberto, S.A.; de Oliveira, C.P. Evaluation of toxic compounds and quality parameters on the aged Brazilian sugarcane spirit. Res. Soc. Dev. Chang. 2020, 9, e395985544. [Google Scholar] [CrossRef]
- Singh, S.; Roy, S.; Prasad, L.; Chauhan, A.S. Bio-Alcohol. In Biofuel Extraction Techniques; Wiley: Hoboken, NJ, USA, 2023; pp. 257–290. [Google Scholar]
- Aguilar-Rivera, N.; Olvera-Vargas, L.A. Impacts of public policies and stakeholders in the transition from the biofuel value chain to a circular bioeconomy: México as a case study. In Advances in Lignocellulosic Biofuel Production Systems; Elsevier: Amsterdam, The Netherlands, 2023; pp. 381–406. [Google Scholar]
- Hendriks, H. Alcohol and human health: What is the evidence? Annu. Rev. Food Sci. Technol. 2020, 11, 1–21. [Google Scholar] [CrossRef] [PubMed]
- Tse, T.J.; Wiens, D.J.; Reaney, M.J. Production of bioethanol—A review of factors affecting ethanol yield. Fermentation 2021, 7, 268. [Google Scholar] [CrossRef]
- Edeh, I. Bioethanol production: An overview. J. Bioeth. Tech. 2021, 1. [Google Scholar] [CrossRef]
- Liu, C.-G.; Li, K.; Wen, Y.; Geng, B.-Y.; Liu, Q.; Lin, Y.-H. Bioethanol: New opportunities for an ancient product. In Advanced Bioenergy; Elsevier: Amsterdam, The Netherlands, 2019; Volume 4, pp. 1–34. [Google Scholar]
- Erasmus, V.; Daha, T.J.; Brug, H.; Richardus, J.H.; Behrendt, M.D.; Vos, M.C.; van Beeck, E.F. Systematic review of studies on compliance with hand hygiene guidelines in hospital care. Infect. Control Hosp. Epidemiol. 2010, 31, 283–294. [Google Scholar] [CrossRef] [PubMed]
- Mahmood, A.; Eqan, M.; Pervez, S.; Alghamdi, H.A.; Tabinda, A.B.; Yasar, A.; Brindhadevi, K.; Pugazhendhi, A. COVID-19 and frequent use of hand sanitizers; human health and environmental hazards by exposure pathways. Sci. Total Environ. 2020, 742, 140561. [Google Scholar] [CrossRef] [PubMed]
- Dal’Belo, S.E.; Rigo Gaspar, L.; Berardo Gonçalves Maia Campos, P.M. Moisturizing effect of cosmetic formulations containing Aloe vera extract in different concentrations assessed by skin bioengineering techniques. Skin. Res. Technol. 2006, 12, 241–246. [Google Scholar] [CrossRef]
- Booq, R.Y.; Alshehri, A.A.; Almughem, F.A.; Zaidan, N.M.; Aburayan, W.S.; Bakr, A.A.; Kabli, S.H.; Alshaya, H.A.; Alsuabeyl, M.S.; Alyamani, E.J.; et al. Formulation and Evaluation of Alcohol-Free Hand Sanitizer Gels to Prevent the Spread of Infections during Pandemics. Int. J. Env. Res. Public Health 2021, 18, 6252. [Google Scholar] [CrossRef]
- Fallica, F.; Leonardi, C.; Toscano, V.; Santonocito, D.; Leonardi, P.; Puglia, C. Assessment of Alcohol-Based Hand Sanitizers for Long-Term Use, Formulated with Addition of Natural Ingredients in Comparison to WHO Formulation 1. Pharmaceutics 2021, 13, 571. [Google Scholar] [CrossRef]
- Dong, S.; Yang, X.; Zhao, L.; Zhang, F.; Hou, Z.; Xue, P. Antibacterial activity and mechanism of action saponins from Chenopodium quinoa Willd. husks against foodborne pathogenic bacteria. Ind. Crops Prod. 2020, 149, 112350. [Google Scholar] [CrossRef]
- Das, S.; Wong, A.B. Stabilization of ferulic acid in topical gel formulation via nanoencapsulation and pH optimization. Sci. Rep. Cetacean Res. 2020, 10, 12288. [Google Scholar] [CrossRef] [PubMed]
- Sitohang, N.A.; Putra, E.D. Effect of various concentrations of Barringtonia racemosa (l). Spreng extract on Physical stability of Topical gel. Res. J. Pharm. Technol. 2023, 16, 4271–4275. [Google Scholar] [CrossRef]
- Setiawan, B.; Fika, R.; Fadhila, M.; Trisna, M.; Putri, L.A. Effect of Different Concentrations of Propylene Glycol and Glycerin on the Formulation of Guava Leaf (Psidium Guajava Linn.) Body Scrub with White Rice (Oryza sativa Linn.). Jurnal Eduhealth 2023, 14, 1332–1336. [Google Scholar] [CrossRef]
- Pérez Zamora, C.M.; Michaluk, A.G.; Torres, C.A.; Mouriño, V.S.L.; Chiappetta, D.A.; Nuñez, M.B. Influence of herbal extracts in physicochemical properties and stability of antibacterial gels. J. Adv. Pharm. Educ. Res. 2023, 13, 16–24. [Google Scholar] [CrossRef]
- Perinelli, D.R.; Berardi, A.; Bisharat, L.; Cambriani, A.; Ganzetti, R.; Bonacucina, G.; Cespi, M.; Palmieri, G.F. Rheological properties of cellulosic thickeners in hydro-alcoholic media: The science behind the formulation of hand sanitizer gels. Int. J. Pharm. 2021, 604, 120769. [Google Scholar] [CrossRef]
- Berardi, A.; Perinelli, D.R.; Bisharat, L.; Sabbatini, B.; Bonacucina, G.; Tiboni, M.; Palmieri, G.F.; Cespi, M. Factors affecting the rheological behaviour of carbomer dispersions in hydroalcoholic medium: Towards the optimization of hand sanitiser gel formulations. Int. J. Pharm. 2022, 616, 121503. [Google Scholar] [CrossRef]
- Mohite, P.B.; Adhav, S.S. A hydrogels: Methods of preparation and applications. Int. J. Adv. Pharm 2017, 6, 79–85. [Google Scholar]
- Sommatis, S.; Capillo, M.C.; Maccario, C.; Rauso, R.; D’Este, E.; Herrera, M.; Castiglioni, M.; Mocchi, R.; Zerbinati, N. Antimicrobial efficacy assessment and rheological investigation of two different hand sanitizers compared with the standard reference WHO formulation 1. Gels 2023, 9, 108. [Google Scholar] [CrossRef] [PubMed]
- Silva, A.F.; Wood, T.A.; Hodgson, D.J.; Royer, J.R.; Thijssen, J.H.; Lips, A.; Poon, W.C. Rheological design of thickened alcohol-based hand rubs. Rheol. Acta 2022, 61, 571–581. [Google Scholar] [CrossRef]
- Shukr, M.; Metwally, G.F. Evaluation of topical gel bases formulated with various essential oils for antibacterial activity against methicillin-resistant Staphylococcus aureus. Trop. J. Pharm. Res. 2013, 12, 877–884. [Google Scholar] [CrossRef]
- Yin, W.-J.; Chen, X.-W.; Ma, C.-G.; Wang, J.-M. Fabrication and characterization of tunable high internal phase emulsion gels (HIPE-Gels) formed by natural triterpenoid saponin and plant soy protein. ACS Food Sci. 2022, 2, 1103–1113. [Google Scholar] [CrossRef]
- Miastkowska, M.; Kulawik-Pióro, A.; Szczurek, M. Nanoemulsion gel formulation optimization for burn wounds: Analysis of rheological and sensory properties. Processes 2020, 8, 1416. [Google Scholar] [CrossRef]
- Surini, S.; Amirtha, N.I.; Lestari, D.C. Formulation and effectiveness of a hand sanitizer gel produced using salam bark extract. Int. J. Appl. Pharm. 2018, 10, 216–220. [Google Scholar] [CrossRef][Green Version]
- Lieberman, H.; Rieger, M.; Banker, G.S. Pharmaceutical Dosage Forms: Disperse Systems; CRC Press: Boca Raton, FL, USA, 2020. [Google Scholar]
- Bonacucina, G.; Spina, M.; Misici-Falzi, M.; Cespi, M.; Pucciarelli, S.; Angeletti, M.; Palmieri, G.F. Effect of hydroxypropyl β-cyclodextrin on the self-assembling and thermogelation properties of Poloxamer 407. Eur. J. Pharm. Sci. 2007, 32, 115–122. [Google Scholar] [CrossRef] [PubMed]
- Winter, H.H. Can the gel point of a cross-linking polymer be detected by the G′-G″ crossover? Polym. Eng. Sci. 1987, 27, 1698–1702. [Google Scholar] [CrossRef]
- Martyasari, N.W.R.; Andayani, Y.; Hajrin, W. Optimisation of hand sanitiser gel formula of Tekelan leaves extract (Chromolaena odorata) using simplex lattice design method. Bali Med. J. 2019, 8, 769–773. [Google Scholar] [CrossRef]
- Golin, A.P.; Choi, D.; Ghahary, A. Hand sanitizers: A review of ingredients, mechanisms of action, modes of delivery, and efficacy against coronaviruses. Am. J. Infect. Control 2020, 48, 1062–1067. [Google Scholar] [CrossRef]
- Hurler, J.; Engesland, A.; Poorahmary Kermany, B.; Škalko-Basnet, N. Improved texture analysis for hydrogel characterization: Gel cohesiveness, adhesiveness, and hardness. J. Appl. Polym. Sci. 2012, 125, 180–188. [Google Scholar] [CrossRef]
- Anvari, M.; Joyner, H.S. Effect of formulation on structure-function relationships of concentrated emulsions: Rheological, tribological, and microstructural characterization. Food Hydrocoll. 2017, 72, 11–26. [Google Scholar] [CrossRef]
- Hamed, R.; Abu Alata, W.a.; Abu-Sini, M.; Abulebdah, D.H.; Hammad, A.M.; Aburayya, R. Development and comparative evaluation of ciprofloxacin nanoemulsion-loaded bigels prepared using different ratios of oleogel to hydrogels. Gels 2023, 9, 592. [Google Scholar] [CrossRef]
- Ramírez Martínez, C. Synthesis and Characterization of a Natural-Based Hydrogel for Biomedical Applications. 2022. Available online: https://repositorio.tec.mx/handle/11285/650868 (accessed on 29 February 2024).
- Teoh, W.K.; Muslim, N.Z.M.; Ismail, M.L.; Chang, K.H.; Abdullah, A.F.L. Quick determination and discrimination of commercial hand sanitisers using attenuated total reflectance-Fourier transform infrared spectroscopy and chemometrics. Anal. Methods 2021, 13, 1601–1611. [Google Scholar] [CrossRef] [PubMed]
- El-Sakhawy, M.; Tohamy, H.-A.S.; AbdelMohsen, M.M.; El-Missiry, M. Biodegradable carboxymethyl cellulose based material for sustainable/active food packaging application. J. Thermoplast. Compos. Mater. 2023, 08927057231211236. [Google Scholar] [CrossRef]
- Xie, D.; Jiang, Y.; Xu, R.; Zhang, Z.; Chen, G. Preparation of ethanol-gels as hand sanitizers formed from chitosan and silica nanoparticles. J. Mol. Liq. 2023, 384, 122276. [Google Scholar] [CrossRef]
- Ahmadi, P.; Jahanban-Esfahlan, A.; Ahmadi, A.; Tabibiazar, M.; Mohammadifar, M. Development of ethyl cellulose-based formulations: A perspective on the novel technical methods. Food Rev. Int. 2022, 38, 685–732. [Google Scholar] [CrossRef]
- Hamed, R.; AbuRezeq, A.; Tarawneh, O. Development of hydrogels, oleogels, and bigels as local drug delivery systems for periodontitis. Drug Dev. Ind. Pharm. 2018, 44, 1488–1497. [Google Scholar] [CrossRef]
- García-Salcedo, Á.J.; Torres-Vargas, O.L.; Ariza-Calderón, H. Physical-chemical characterization of quinoa (Chenopodium quinoa Willd.), amaranth (Amaranthus caudatus L.), and chia (Salvia hispanica L.) flours and seeds. Acta Agronon. 2018, 67, 215–222. [Google Scholar]
- Liao, Y.; Li, Z.; Zhou, Q.; Sheng, M.; Qu, Q.; Shi, Y.; Yang, J.; Lv, L.; Dai, X.; Shi, X. Saponin surfactants used in drug delivery systems: A new application for natural medicine components. Int. J. Pharm. 2021, 603, 120709. [Google Scholar] [CrossRef]
- Thiruvengadam, V.; Bansod, A. Characterization of silver nanoparticles synthesized using chemical method and its antibacterial property. Biointerface Res. Appl. Chem. 2020, 10, 7257–7264. [Google Scholar]
- Wanger, A.; Chávez, V. Antibiotic susceptibility testing. In Practical Handbook of Microbiology; CRC Press: Boca Raton, FL, USA, 2021; pp. 119–128. [Google Scholar]
- Kachur, K.; Suntres, Z. The antibacterial properties of phenolic isomers, carvacrol and thymol. Crit. Rev. Food Sci. Nutr. 2020, 60, 3042–3053. [Google Scholar] [CrossRef]
- Strahilevitz, J.; Rubinstein, E. Novel agents for resistant Gram-positive infections—A review. Int. J. Infect. Dis. 2002, 6, S38–S46. [Google Scholar] [CrossRef][Green Version]
- Durán, N.; Durán, M.; de Jesus, M.B.; Seabra, A.B.; Fávaro, W.J.; Nakazato, G. Silver nanoparticles: A new view on mechanistic aspects on antimicrobial activity. Nanomed. Nanotechnol. Biol. Med. 2016, 12, 789–799. [Google Scholar] [CrossRef] [PubMed]
- Prasad, S.R.; Teli, S.B.; Ghosh, J.; Prasad, N.R.; Shaikh, V.S.; Nazeruddin, G.M.; Al-Sehemi, A.G.A.; Patel, I.; Shaikh, Y.I. A Review on Bio-inspired Synthesis of Silver Nanoparticles: Their Antimicrobial Efficacy and Toxicity. Eng. Sci. 2021, 16, 90–128. [Google Scholar] [CrossRef]
- Mora-Ocación, M.S.; Morillo-Coronado, A.C.; Manjarres-Hernández, E.H. Extraction and Quantification of Saponins in Quinoa (Chenopodium quinoa Willd.) Genotypes from Colombia. Int. J. Food Sci. 2022, 2022, 7287487. [Google Scholar] [CrossRef] [PubMed]
- Anju, T.R.; Parvathy, S.; Valiya Veettil, M.; Rosemary, J.; Ansalna, T.H.; Shahzabanu, M.M.; Devika, S. Green synthesis of silver nanoparticles from Aloe vera leaf extract and its antimicrobial activity. Mater. Today Proc. 2021, 43, 3956–3960. [Google Scholar] [CrossRef]
- Chinnasamy, G.; Chandrasekharan, S.; Koh, T.W.; Bhatnagar, S. Synthesis, Characterization, Antibacterial and Wound Healing Efficacy of Silver Nanoparticles from Azadirachta indica. Front. Microbiol. 2021, 12, 611560. [Google Scholar] [CrossRef] [PubMed]
- Amraei, S.; Ahmadi, S. Recent studies on antimicrobial and anticancer activities of saponins: A mini-review. Nano Micro Biosyst. 2022, 1, 22–26. [Google Scholar]
- Alqarni, M.H.; Foudah, A.I.; Alam, A.; Salkini, M.A.; Muharram, M.M.; Labrou, N.E.; Kumar, P. Development of gum-acacia-stabilized silver nanoparticles gel of rutin against Candida albicans. Gels 2022, 8, 472. [Google Scholar] [CrossRef] [PubMed]
- Song, K.-W.; Kim, Y.-S.; Chang, G.-S. Rheology of concentrated xanthan gum solutions: Steady shear flow behavior. Fibers Polym. 2006, 7, 129–138. [Google Scholar] [CrossRef]
- Herschel, W.H.; Bulkley, R. Consistency measurements of rubber-benzene solutions. Kolloid-Zeitschrift 1926, 39, 291–300. [Google Scholar] [CrossRef]
- Casson, N. A flow equation for pigment-oil suspensions of the printing ink type. In Rheology of Disperse Systems; Pergamon Press: Oxford, UK, 1959; pp. 84–104. [Google Scholar]
- Li, S.P.; Zhao, G.; Chen, H.Y. The Relationship between Steady Shear Viscosity and Complex Viscosity. J. Dispersion Sci. Technol. 2005, 26, 415–419. [Google Scholar] [CrossRef]
- Beć, K.B.; Grabska, J.; Huck, C.W. Near-infrared spectroscopy in bio-applications. Molecules 2020, 25, 2948. [Google Scholar] [CrossRef] [PubMed]
- Bauer, A.W.; Kirby, W.M.; Sherris, J.C.; Turck, M. Antibiotic susceptibility testing by a standardized single disk method. Am. J. Clin. Pathol. 1966, 45, 493–496. [Google Scholar] [CrossRef] [PubMed]

| Components | Samples | |||||||
|---|---|---|---|---|---|---|---|---|
| (%) | GAA1 | GAA2 | GAA3 | GAA4 | GAA5 | GAA6 | GAA7 | GAA8 |
| Ethyl alcohol | 93.2 | 91.6 | 90.2 | 88.8 | 92.6 | 91.0 | 89.6 | 88.2 |
| Carbopol | 0.5 | 0.5 | 0.5 | 0.5 | 0.5 | 0.5 | 0.5 | 0.5 |
| Triethanolamine | 0.3 | 0.3 | 0.3 | 0.3 | 0.3 | 0.3 | 0.3 | 0.3 |
| Propanediol | 4.5 | 4.5 | 4.5 | 4.5 | 4.5 | 4.5 | 4.5 | 4.5 |
| Silver nanoparticles | - | - | - | - | 0.6 | 0.6 | 0.6 | 0.6 |
| Quinoa saponins | 1.5 | 3.1 | 4.5 | 5.9 | 1.5 | 3.1 | 4.5 | 5.9 |
| Samples | pH | Visual Appearance | Visual Viscosity | Smell Characteristic | Lumps |
|---|---|---|---|---|---|
| GC | 6.30 ± 0.01 e | Clear + Bubbles | Semi fluid | Alcohol | - |
| GAA1 | 6.58 ± 0.02 c | Clear + Bubbles | Semi fluid | Alcohol + Puntas | - |
| GAA2 | 6.40 ± 0.02 d | Clear + Bubbles | Semi fluid | Alcohol + Puntas | - |
| GAA3 | 6.58 ± 0.01 c | Clear + Bubbles | Semi fluid | Alcohol + Puntas | - |
| GAA4 | 6.69 ± 0.01 b | Clear + Bubbles | Semi fluid | Alcohol + Puntas | - |
| GAA5 | 6.68 ± 0.02 b | Clear + Bubbles | Semi fluid | Alcohol + Puntas | - |
| GAA6 | 6.38 ± 0.01 d | Clear + Bubbles | Semi fluid | Alcohol + Puntas | - |
| GAA7 | 6.58 ± 0.01 c | Clear + Bubbles | Semi fluid | Alcohol + Puntas | - |
| GAA8 | 6.75 ± 0.01 a | Clear + Bubbles | Semi fluid | Alcohol + Puntas | - |
| Treatments | Models | |||
|---|---|---|---|---|
| Model Constants and r2 Adjustment | Power Law | Herschel–Bulkley | Casson | |
| GC | Model constants | k: 2.093 n: 0.894 | σ0: 4.472 × 10−4 k: 2.088 n: 0.870 | σ0: 0.769 k: 0.933 |
| Adj. r2 | 0.992 | 0.992 | 0.945 | |
| GAA1 | Model constants | k: 1.437 n: 0.893 | σ0: 4.789 × 10−5 k: 1.437 n: 0.868 | σ0: 0.702 k: 0.771 |
| Adj. r2 | 0.992 | 0.992 | 0.945 | |
| GAA2 | Model constants | k: 1.830 n: 0.889 | σ0: 3.975 × 10−4 k: 1.826 n: 0.863 | σ0: 0.748 k: 0.862 |
| Adj. r2 | 0.991 | 0.991 | 0.946 | |
| GAA3 | Model constants | k: 2.303 n: 0.909 | σ0: 1.387 × 10−4 k: 2.302 n: 0.887 | σ0: 0.755 k: 1.029 |
| Adj. r2 | 0.993 | 0.993 | 0.953 | |
| GAA4 | Model constants | k: 2.404 n: 0.906 | σ0: 3.734 × 10−4 k: 2.400 n: 0.883 | σ0: 0.774 k: 1.038 |
| Adj. r2 | 0.993 | 0.993 | 0.951 | |
| GAA5 | Model constants | k: 1.602 n: 0.877 | σ0: 1.839 × 10−4 k: 1.600 n: 0.850 | σ0: 0.748 k: 0.773 |
| Adj. r2 | 0.990 | 0.990 | 0.936 | |
| GAA6 | Model constants | k: 2.124 n: 0.898 | σ0: 4.992 × 10−4 k: 2.119 n: 0.874 | σ0: 0.764 k: 0.952 |
| Adj. r2 | 0.992 | 0.992 | 0.948 | |
| GAA7 | Model constants | k: 2.360 n: 0.913 | σ0: 4.803 × 10−4 k: 2.355 n: 0.894 | σ0: 0.745 k: 1.061 |
| Adj. r2 | 0.994 | 0.994 | 0.958 | |
| GAA8 | Model constants | k: 2.437 n: 0.886 | σ0: 2.194 × 10−4 k: 2.435 n: 0.859 | σ0: 0.812 k: 0.982 |
| Adj. r2 | 0.991 | 0.991 | 0.943 | |
| Sample | Hardness (g) | Elasticity (mm) |
|---|---|---|
| GC | 113.02 ± 0.03 a | 7.47 ± 0.05 f |
| GAA1 | 101.00 ± 0.04 b | 8.07 ± 0.04 e |
| GAA2 | 89.00 ± 0.01 e | 9.74 ± 0.05 a |
| GAA3 | 96.00 ± 0.04 c | 7.86 ± 0.03 g |
| GAA4 | 89.00 ± 0.03 e | 9.22 ± 0.02 b |
| GAA5 | 93.00 ± 0.04 d | 9.32 ± 0.03 b |
| GAA6 | 88.00 ± 0.03 f | 9.81 ± 0.03 a |
| GAA7 | 87.00 ± 0.02 g | 8.29 ± 0.04 d |
| GAA8 | 86.00 ± 0.02 h | 8.96 ± 0.02 c |
| Samples | S. aureus (mm) | E. coli (mm) |
|---|---|---|
| GC | 9.75 ± 0.02 b | 11.50 ± 0.02 b |
| GAA1 | 7.50 ± 0.03 g | 8.75 ± 0.03 g |
| GAA2 | 9.00 ± 0.01 d | 9.00 ± 0.01 f |
| GAA3 | 9.75 ± 0.03 b | 8.00 ± 0.03 h |
| GAA4 | 8.75 ± 0.04 e | 10.75 ± 0.04 c |
| GAA5 | 11.50 ± 0.02 a | 12.12 ± 0.02 a |
| GAA6 | 8.75 ± 0.04 e | 9.00 ± 0.04 f |
| GAA7 | 8.00 ± 0.02 f | 9.25 ± 0.02 e |
| GAA8 | 9.62 ± 0.03 c | 10.62 ± 0.03 d |
| Model | Equation | Equation Number | References |
|---|---|---|---|
| Power law | (1) | [85] | |
| Herschel–Bulkley | (2) | [86] | |
| Casson | (3) | [87] |
Disclaimer/Publisher’s Note: The statements, opinions and data contained in all publications are solely those of the individual author(s) and contributor(s) and not of MDPI and/or the editor(s). MDPI and/or the editor(s) disclaim responsibility for any injury to people or property resulting from any ideas, methods, instructions or products referred to in the content. |
© 2024 by the authors. Licensee MDPI, Basel, Switzerland. This article is an open access article distributed under the terms and conditions of the Creative Commons Attribution (CC BY) license (https://creativecommons.org/licenses/by/4.0/).
Share and Cite
Analuiza, O.; Paredes, B.; Lascano, A.; Bonilla, S.; Martínez-Guitarte, J.-L. Development and Characterization of a Hand Rub Gel Produced with Artisan Alcohol (Puntas), Silver Nanoparticles, and Saponins from Quinoa. Gels 2024, 10, 234. https://doi.org/10.3390/gels10040234
Analuiza O, Paredes B, Lascano A, Bonilla S, Martínez-Guitarte J-L. Development and Characterization of a Hand Rub Gel Produced with Artisan Alcohol (Puntas), Silver Nanoparticles, and Saponins from Quinoa. Gels. 2024; 10(4):234. https://doi.org/10.3390/gels10040234
Chicago/Turabian StyleAnaluiza, Oscar, Belen Paredes, Alejandra Lascano, Santiago Bonilla, and José-Luis Martínez-Guitarte. 2024. "Development and Characterization of a Hand Rub Gel Produced with Artisan Alcohol (Puntas), Silver Nanoparticles, and Saponins from Quinoa" Gels 10, no. 4: 234. https://doi.org/10.3390/gels10040234
APA StyleAnaluiza, O., Paredes, B., Lascano, A., Bonilla, S., & Martínez-Guitarte, J.-L. (2024). Development and Characterization of a Hand Rub Gel Produced with Artisan Alcohol (Puntas), Silver Nanoparticles, and Saponins from Quinoa. Gels, 10(4), 234. https://doi.org/10.3390/gels10040234

